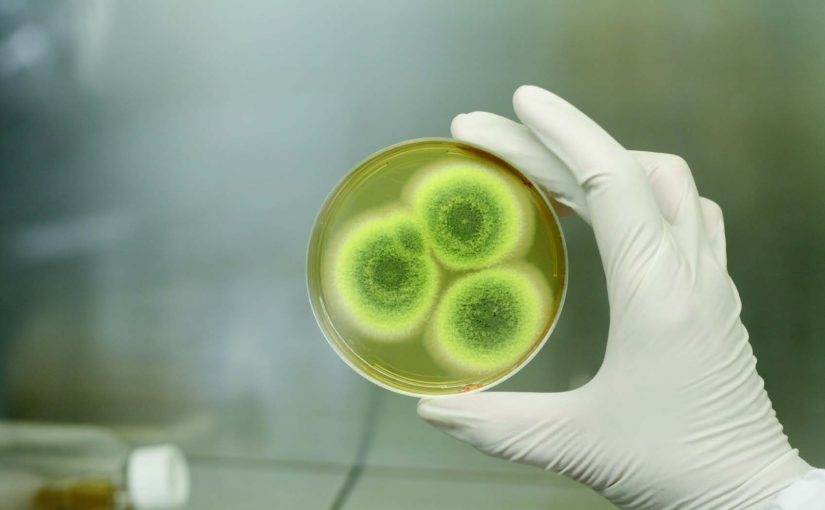
Asian Tigers Canada Day

Moving tips: How to prevent mould & mildew in shipment?
A Word About Mould & Mildew:
Mould & mildew are microscopic fungal cells that thrive in humid climates. Mould & mildew spores easily move from place to place through airborne transmission. There are mildew cells present on almost all surfaces, but especially on cloth,leather and paper.
Mould & Mildew and Your Shipment: Mould & mildew can exist on clothing, leather and similar surfaces, so it is a potential risk to your shipment. Of course, we do not introduce mould & mildew spores – they are already in the atmosphere. However, once items are wrapped and packed away, these pre-existing mould & mildew spores can “bloom” or enter a rapid reproduction phase under the right conditions. This is how mould & mildew damage occurs, and it is virtually impossible to prevent.
Can You Do Anything to Prevent Mould & Mildew?
Not completely, but there are steps you can take to reduce the risks. You can reduce humidity and moisture content by operating air conditioners and dehumidifiers in the weeks leading up to your packing. Ask your mover to use silica gel packets to help absorb moisture. Consider Absorbmatic bars for the inside of your container. These, and similar steps, will reduce but not altogether eliminate the risk of mould & mildew damage.
Can You Claim Compensation if Your Goods are Damaged by Mould & Mildew?
You can, but only if you have Mould & Mildew insurance coverage. This is vitally important and we strongly urge you to fully insure your shipment – not only from mould & mildew, but other common risks that are inherent with international shipments of household goods and personal effects. If you have further questions, please speak with your Asian Tigers relocation consultant.